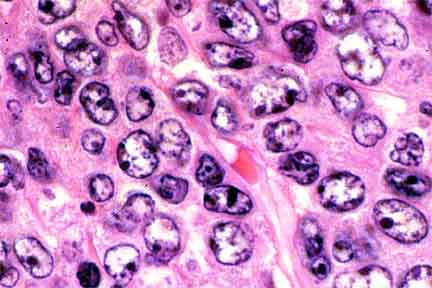

Go to:

TOC
|
Diffuse Large Cell Lymphomas
 The overall appearance is pink because the nuclei are open and the cells have moderate amounts of eosinophilic cytoplasm. |
Although the general cell type is large (defined as having a nucleus larger than that of a macrophage or endothelial cell), there is considerable variation in cell size and shape. |
 Several of these cells are excellent examples of the typical cell of large cell lymphoma, the centroblast. It has open (clear) chromatin and several moderately large nucleoli that cling to the nuclear membrane. |
Table of Contents
|